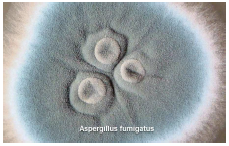

How Long Does It Take Mold to Become Visible?

How Long Does It Take Mold to Become Visible?


Meet Ed
Instructor Ed Jones has over 30 years of experience in theindustry, has the title of MasterWater Restorer, is an Institute ofInspection Cleaning andRestoration Certification (IICRC)-approved instructor, and hasserved on the S500-2021consensus body committee todevelop the most recent standard.
There are estimated over 1.5 million species of mold on this planet (Gravesen S. et al 1994), so mold is virtually everywhere. Mold requires moisture, organic food source, temperature (56-86 degrees F), stagnant air and time to grow. You just have to remove one of those ingredients to stop mold from growing. Dr. Dan Bernazzani says, “Like any living organism, fungi (mold) go through various stages of growth. Fungi grow on surfaces - not in the air. Spores, or hyphal fragments, begin to grow on surfaces when all of their growth requirements are present (moisture, temperature, stagnant air and food source). Given sufficient time, when fungi are present on a surface, and all the conditions for growth are met, they begin the lag phase – not a lot going on but like a young child they begin to grow, slowly at first until they enter the log phase. During the log phase rapid growth occurs as fungi “matures”. This only occurs when there is an abundance of all the above requirements followed by the stationary phase when nutrient sources are depleted.”
Accuserve has conducted many experiments at our IICRC approved ASD flood house in Springfield, OH, called the Disaster Recovery Learning Lab on the Clark State College campus. In our mold growth experiment, we placed OSB subfloor, carpet cushion (pad), tack strip, Saxony carpet, green board drywall, normal drywall, 2x4 sill plate/stud and wood baseboard into a plastic container and saturated all those materials with water. No water was extracted from those materials, and a plastic top was placed on the container to create an airtight chamber. Through a small hole in the top thermo-hygrometer readings were taken daily and the materials were examined closely for visible mold growth each day without the use of a microscope. Facemask & gloves worn during inspections.
After 24 hours the temperature in the container was 77.3 degrees F, relative humidity was 71.4% and GPP was 100.5. These conditions represent a very humid environment where mold would have all the ingredients necessary to grow (stagnant air, organic food source, moisture, and suitable temperature). The relative humidity remained over 70% during the entire experiment (3 weeks) and actually exceeded 85% after the first week. The GPP ranged between 88- 105 gpp.

The mold growth experiment was repeated over a dozen times with the following conclusions:
- No visible mold growth on any of the above-mentioned materials at similar conditions until after 5-6 days of being wet.
- The first mold growth became visible to the naked eye on the 2x4 and the normal drywall paper sometimes on day 5 and sometimes on day 6.
- Mold became visible on green board drywall within several days after it appeared on normal drywall.
- Mold became visible on OSB after 2 weeks of being wet.
- After 2 weeks most of the materials had visible mold on them except carpet and cushion (pad).
- After 3 weeks of being wet the drywall paper had a thick coat of furry mold, the OSB had a white mold and the 2x4 had green specks of mold.
- After 3 weeks of being wet the carpet only exhibited rust stains from the tack strip and there still wasn’t any mold visible on the carpet cushion (pad).
- There was a strong musty/moldy odor when removing the top of the container after 3 weeks.
- Dirtier materials used in some experiments seem to speed up the growth of mold approximately one day.
- Temperature in the incubator was increased during one experiment with a portable heater to make it 90 degrees F/95% Relative Humidity inside the container, and we were able to get the mold to show up on day 4 on a wood material (about the size of your little fingernail).

Summary:
You can grow mold in a plastic container quicker than you could grow it in your home for our homes breathe and the moisture in your home would seek equilibrium with the indoor environment allowing it to dry on its own to some extent thus prolonging the time for mold to become visible. Most water losses we don’t really know how long the materials have been wet, but in many cases, they are wet longer than we think, especially if we find dark staining, deterioration, or visible mold that we think came from that water loss occurrence.
To inspect for potential mold growth go to where it was the wettest, the longest, closest to the origin of loss, on an organic food source for mold, which is typically on wood baseboard, wood sill plate, or drywall paper. Open up just that small area and inspect for mold on the front and back of the materials taking good photos of the results (cut out drywall below the top of the baseboard line to inspect inside the wall) so the baseboard can be reinstalled. Based on your findings you can estimate if the visible mold found was there for days, weeks, or months depending on the darkness of the staining, the amount of mold discovered, and the deterioration of the material.
Mold does grow exponentially so if left wet enough, long enough the mold will grow quickly and spread to other wet materials if they are an organic food source for mold.
Different mold species grow quicker in certain environments. *See Water Activity Chart below which is a good predictor of when certain species of mold can survive

Try your own mold experiment and be sure to include your kids for science can be fun!


